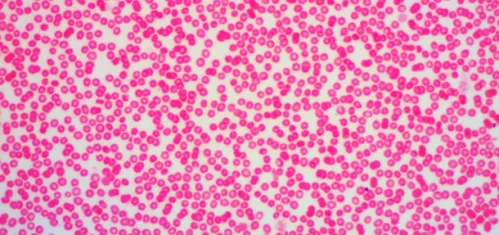
foto Microscopio trinocular digital Levenhuk D670T 5.1M,  11

Microscopio trinocular digital Levenhuk D670T 5.1M
Microscopio digital con cabezal trinocular y cámara de 5 Mpx
| ID de producto | 40029 |
| Marca | Levenhuk, Inc., USA |
| Garantía | toda la vida |
| EAN | 0611901508481 |
| Tamaño de paquete (LxAn.xAl.) | 37x22x42 cm |
| Peso del envío | 5.75 kg |
El Levenhuk D670T 5.1M es un microscopio digital moderno, fiable y fácil de utilizar con cabezal trinocular. Este diseño ofrece la máxima comodidad durante observaciones prolongadas. Con su cámara de 5 Mpx (incluida en el kit estándar) podrás obtener imágenes de sorprendente calidad, que podrás guardar para su uso en el futuro. Puedes también estudiar muestras con gran detalle y en tiempo real en la pantalla de tu ordenador.
El Levenhuk D670T 5.1M ofrece ampliaciones entre 40x y 2000x. Las grandes ampliaciones resultan útiles en estudios de medicina y biología. El Levenhuk D670T 5.1M incluye cuatro lentes de objetivo de gran calidad: 4x, 10x, 40x y 100x (inmersión en aceite).
Al conectar la cámara al cabezal trinocular del microscopio se aumenta aún más el alcance de sus capacidades. Los dos oculares en configuración binocular reducen el esfuerzo de tus ojos en las observaciones prolongadas. Además, están inclinador 30 grados, de forma que puedes sentarte cómodamente a trabajar al microscopio. El cabezal trinocular puede girarse 360 grados sobre su eje, muy útil para trabajar en grupo.
El kit de este microscopio incluye todo lo necesario para empezar a trabajar. La cámara digital incluye un CD de instalación con el software y los controladores necesarios. El Levenhuk D670T y su cámara con compatibles con Windows, Linux y Mac OS.
Características:
- Ampliación del microscopio: 40–2000x
- Cabezal trinocular rotativo
- Imágenes de gran calidad en todo el campo de visión
- La platina se mueve en dos ejes
- Revólver giratorio con 4 lentes
- Iluminación con brillo variable
- Posibilidad de tomar fotos y vídeos
El kit incluye:
- Microscopio digital Levenhuk
- Cabezal trinocular rotativo
- Revólver giratorio con 4 lentes
- 5Mpx cámara digital
- Oculares: WF10x y WF20x
- Objetivos: 4x, 10x, 40x, 100x con aceite
- Filtro azul
- Aceite para inmersión
- Platina: 115x125 mm, móvil
- Condensador: Abbe con diafragma de iris
- Lámpara halógena 6V/20W
- Cable de alimentación*
- CD de configuración Levenhuk
- Funda
- Manual de usuario y garantía de por vida
* Precaución: Consulta en la tabla de especificaciones el voltaje correcto y nunca enchufes un dispositivo de 110V a un enchufe de 220V o viceversa sin utilizar un adaptador. Recuerda que el voltaje en Estados Unidos y Canadá es de 110V y en la mayoría de los países europeos es de 220–240V.
La última versión de Levenhuk para Windows (fecha de lanzamiento: 20/11/2013) está en ocho idiomas: Inglés, francés, alemán, polaco, ruso, chino simplificado, chino tradicional y turco.
Algunas de las cosas que pueden verse al microscopio:





El microscopio trinocular digital Levenhuk D670T 5.1M es además compatible con las cámaras digitales Levenhuk (las cámaras adicionales se venden por separado). Las cámaras Levenhuk se instalan en el tubo del ocular en lugar del mismo.
| ID de producto | 40029 |
| Marca | Levenhuk, Inc., USA |
| Garantía | toda la vida |
| EAN | 0611901508481 |
| Tamaño de paquete (LxAn.xAl.) | 37x22x42 cm |
| Peso del envío | 5.75 kg |
| Tipo | biológico, luz/óptico, digital |
| Tipo de cabezal del microscopio | trinocular |
| Material de óptica | vidrio óptico |
| Cabezal | giratorio 360° |
| Ángulo de inclinación de cabezal | 30° |
| Ampliación, x | 40 — 2000 |
| Diámetro del tubo del ocular, mm | 23.2 |
| Oculares | WF10x, WF20x |
| Objetivos | 4x/0,1; 10x/0,25; 40x/0,65; 100x/1,25 (inmersión en aceite) |
| Revólver | para 4 objetivos |
| Platina, mm | 125x115 |
| Platina | con movimiento coordinado |
| Condensador | Abbe N.A. 1,25 |
| Diafragma | iris |
| Enfoque | aproximado: 20 mm, preciso: 0,002 mm |
| Iluminación | halógena |
| Ajuste del brillo | ✓ |
| Alimentación | 220 V/50 Hz |
| Idioma del software | ruso |
| Imagen | *.jpg, *.bmp, *.png, *.tif, *.gif, *.psd, *.ico, etc. |
| Aplicación | laboratorio/médico |
| Ubicación de la iluminación | inferior |
| Método de investigación | campo claro |
| Cámara digital incluida | ✓ |
| Megapíxeles | 5 |
| Elemento sensor | 1/2,5" |
| Formato de vídeo | *.wmv, *.h264, *.avi (grabación); *.wmv, *.asf, *.avi, *.mp4, *.m4v, *.3gp, *.3g2, *.3gpp, *.mov, *.mkv, *.flv, *.rm, *.rmvb, *.h264, *.h265 (lectura solo) |
| Lugar de uso | tubo del ocular (reemplaza a un ocular) |
| Software, controladores | controlador USB 2.0, programa para cámara Levenhuk (para Mac y Linux utilice Levenhuk Image Editor) |
| Salida | USB 2.0 |
| Requisitos del sistema | Windows XP (32-bit), Windows Vista/7/8/10 (32-bit o 64-bit), Mac OS X, Linux; procesador mínimo Intel Core 2 2,8 GHz, 2 GB de RAM, puerto USB 2.0, CD-ROM |
Hemos recopilado respuestas a las preguntas más frecuentes para ayudarle a ordenar las cosas